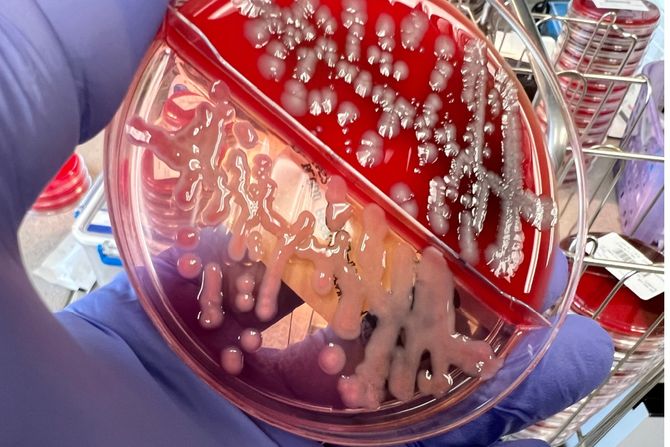

Klebsiella pneumoniae u urinu: zašto se ove infekcije vraćaju izbog čega ih je sve teže lečiti
Infekcije mokraćnih puteva spadaju među najčešće bakterijske infekcije, naročito kod žena i starijih osoba. U većini slučajeva uzrok je poznata bakterija E. coli, ali lekari sve češće upozoravaju na drugog, znatno opasnijeg protivnika. Reč je o bakteriji Klebsiella pneumoniae, koja može izazvati uporne, ponavljane i terapijski izuzetno zahtevne urinarne infekcije.
Ova bakterija prirodno može postojati u organizmu bez simptoma, ali kada dospe u mokraćne puteve, posebno kod osoba sa oslabljenim imunitetom ili hroničnim bolestima, može izazvati ozbiljne probleme koji traju mesecima.
Kako se Klebsiella pneumoniae pojavljuje u urinu
Klebsiella pneumoniae najčešće izaziva urinarne infekcije kod osoba koje su bile hospitalizovane, imale urinarni kateter ili su već više puta lečene antibioticima. Dugotrajna i ponavljana upotreba antibiotika stvara idealne uslove da ova bakterija razvije otpornost i preživi terapije koje su ranije bile efikasne.
Zbog toga se infekcija često vraća ubrzo nakon završetka terapije. Pacijenti imaju osećaj da se nikada u potpunosti nisu izlečili, iako su analize urina privremeno bile uredne.
Simptomi koji ne treba da se ignorišu
Kada je Klebsiella pneumoniae prisutna u urinu, simptomi su slični drugim urinarnim infekcijama, ali često traju duže i teže prolaze. Najčešće se javljaju peckanje i bol pri mokrenju, učestala i hitna potreba za mokrenjem, bol u donjem delu stomaka i zamućen ili neprijatno mirisan urin. Kod težih slučajeva mogu se javiti povišena temperatura, slabost i bol u donjem delu leđa, što ukazuje da se infekcija širi ka bubrezima.
Kod starijih osoba simptomi mogu biti netipični i uključivati konfuziju, opštu slabost ili naglo pogoršanje postojećih hroničnih bolesti.
Zašto je ovu bakteriju teško iskoreniti
Jedan od ključnih problema kod Klebsiella pneumoniae jeste njena sposobnost da stvara biofilm. To je zaštitni sloj u kome se bakterije „skrivaju“, čime postaju nedostupne antibioticima i imunom sistemu. Zbog biofilma, bakterija može opstajati u mokraćnim putevima i nakon naizgled uspešne terapije.
Dodatni problem je višestruka otpornost na antibiotike. Mnogi sojevi Klebsiella pneumoniae danas su otporni na antibiotike koji se rutinski koriste kod urinarnih infekcija, uključujući beta-laktame i fluorohinolone. U nekim slučajevima bakterija pokazuje otpornost čak i na antibiotike koji se smatraju poslednjom linijom odbrane.
Može li stari lek imati novu ulogu
Novo naučno istraživanje, sprovedeno kod pacijenata sa upornim urinarnim infekcijama izazvanim multirezistentnom Klebsiella pneumoniae, donosi oprezno ohrabrujuće rezultate. Studija je pokazala da trimetoprim-sulfametoksazol, antibiotik koji se danas ređe koristi, može biti efikasna terapijska opcija kada se primenjuje pažljivo, dugotrajno i uz strogu kontrolu.
Kod pacijenata koji su prethodno imali više neuspešnih terapija, primena ovog antibiotika u jasno definisanom režimu dovela je do potpunog nestanka bakterije iz urina i povlačenja simptoma. Važno je naglasiti da su pacijenti birani vrlo pažljivo, na osnovu antibiograma, i da terapija nije bila kratkotrajna.
Ovaj nalaz je značajan jer ukazuje da pojedini stariji antibiotici, koji se danas ređe koriste, mogu ponovo dobiti mesto u lečenju, upravo zato što bakterije prema njima nisu razvile masovnu otpornost.
Zašto terapija mora biti individualna
Iako ovi rezultati ulivaju nadu, stručnjaci upozoravaju da ne postoji univerzalno rešenje. Terapija Klebsiella pneumoniae u urinu mora biti strogo individualna i zasnovana na laboratorijskim analizama, funkciji bubrega, prisustvu drugih bolesti i opštem stanju pacijenta.
Dugotrajna antibiotska terapija nosi i određene rizike, uključujući poremećaje krvne slike, elektrolitni disbalans, alergijske reakcije i opterećenje jetre i bubrega. Zato se ovakvi režimi sprovode isključivo pod nadzorom lekara.
Šta pacijenti mogu da urade
Ako se urinarnе infekcije stalno vraćaju, a u nalazima se ponavlja Klebsiella pneumoniae, važno je ne prihvatati ponavljanje istih terapija bez jasnog plana. Neophodni su ponovljeni urinokulture, antibiogrami i konsultacije sa infektologom ili nefrologom.
Samoinicijativno uzimanje antibiotika, prekid terapije pre vremena ili „čuvanje“ lekova za kasnije može dodatno pogoršati problem i povećati otpornost bakterije.
Bakterija otporna na antibiotike
Klebsiella pneumoniae u urinu nije bezazlena bakterija i ne treba je potcenjivati. Ona je jedan od razloga zašto se sve više govori o otpornosti na antibiotike i potrebi za pametnim, ciljanim lečenjem. Ipak, nova istraživanja pokazuju da i u takvim slučajevima postoji prostor za uspešnu terapiju, uz strpljenje, preciznu dijagnostiku i individualni pristup.
(eKlinika.rs)
eKlinika zadržava sva prava nad sadržajem. Za preuzimanje sadržaja pogledajte uputstva na stranici Uslovi korišćenja.



